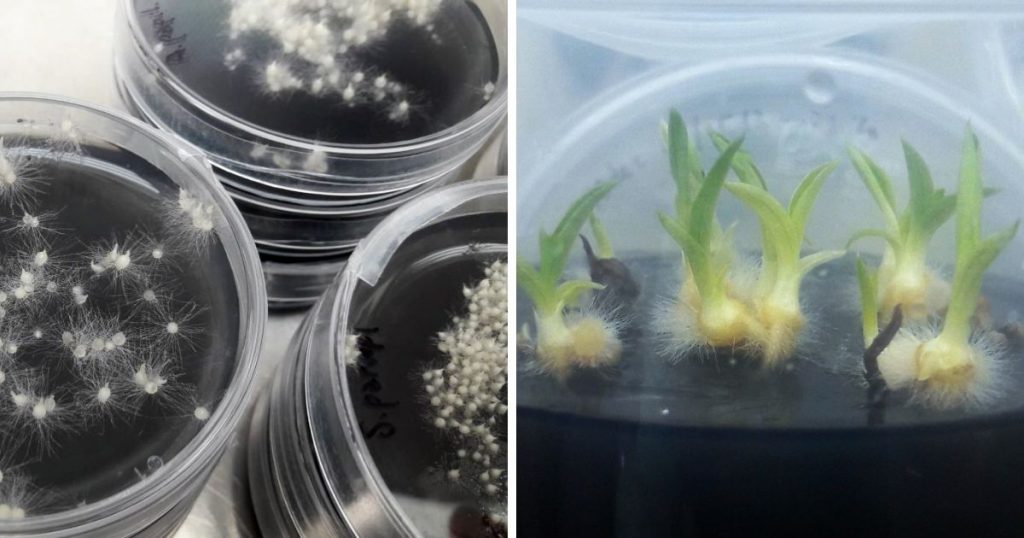

LO SPECIALE LEOPOLDO DI LORENA
GROSSETO. Dall’aprile 2019, il Crisba, in collaborazione con Acquedotto del Fiora S.p.A., porta avanti un progetto che salvaguarda le orchidee della pineta maremmana di Marina di Grosseto, site nella zona limitrofa all’Oasi San Felice, tramite il monitoraggio delle popolazioni spontanee e la propagazione da seme in vitro delle specie presenti, così da costituire una collezione per una eventuale reintroduzione in natura che vada a sostenere quella già presente, soprattutto se a rischio.

IL Crisba
Il Crisba (www.crisba.eu), fondato a Grosseto all’interno dell’Istituto Superiore ISIS “Leopoldo II di Lorena” nel Luglio 2010, è un centro ricerche che svolge attività di sperimentazione scientifica in ambito agro-alimentare e ambientale, con il coinvolgimento di studenti e di aziende provenienti da tutto il territorio nazionale.
Gli studi del Centro riguardano in particolar modo l’innovazione e la sicurezza alimentare della filiera cerealicola, la biodifesa delle colture vegetali, la tutela della biodiversità locale protetta e, su commissione, lo svolgimento di prove agronomiche.
Per sapere di più sul Crisba leggi qui: Crisba, il centro ricerche avanzato del Tecnico Agrario.
Il progetto delle orchidee
Seguendo il filone che si occupa della flora, da 11 anni il CRISBA è attivo sulla tutela delle piante dunali, come il Giglio di Mare (Pancratium maritimum), che dal suo seme viene propagato nei loro laboratori e poi piantumato nelle dune per il ripopolamento. Stessa sorte seguono piante dunali come l’Ammofila (Ammophila arenaria), la Camomilla marina (Anthemis maritima), la Gramigna delle spiagge (Agropyron junceum) seguendo il ritmo di una piantumazione all’anno, da Capalbio fino a Castiglione della Pescaia e Scarlino.
Come racconta Lorenzo Moncini: «Visto che abbiamo avuto un buon riscontro sul progetto, in termini di sensibilizzazione di studenti e collettività alla tutela della flora locale, e che abbiamo tecnologie e competenze adatte anche alla coltivazione e propagazione in vitro, abbiamo scelto di ampliare le nostre attività. Tutto è stato possibile anche grazie alla collaborazione promossa da Giorgini con Acquedotto del Fiora, così siamo riusciti a coinvolgere nei nostri progetti le orchidee di Marina di Grosseto, con le quali Gabriele Simone, il nostro ricercatore, ha particolare familiarità».

Il nostro territorio risulta ospitare un gran numero di orchidee spontanee, alcune delle quali presenti nella pineta di Marina di Grosseto, un habitat soggetto a diverse minacce tra cui quella degli incendi boschivi: anche per questo le attività di tutela, propagazione e piantumazione possono solo che essere utile.
Il progetto è iniziato monitorando per due anni le orchidee presenti in un’area della pineta, censendo una popolazione di circa 13 specie differenti. Sono stati stilati report e il lavoro è stato presentato anche al Museo di Storia Naturale di Grosseto durante la Notte dei Ricercatori dello scorso settembre. A questa attività è seguita quella del campionamento dei semi.

Moncini specifica: «Le orchidee generalmente non riescono a germinare se non in presenza di funghi simbionti. Con la coltura in vitro invece riusciamo ad eludere questa simbiosi, facendo germinare le orchidee senza l’utilizzo di funghi. La propagazione in vitro ci permette di propagare la pianta in poco spazio, senza terreno, in ambiente asettico, tramite nutrizione e illuminazione artificiali. Lo step successivo sarà l’osservazione della fase di accrescimento e, una volta che i tuberi saranno formati, verranno poi rimessi in natura. Adesso abbiamo molte orchidee in propagazione nei contenitori in vitro, più alcuni esemplari per i quali stiamo portando avanti in questi giorni la fase di ambientamento in serra, ponendoli in vaso su terreno naturale. Una fase delicata, come sempre lo è la fase di transizione dal vitro, in ambiente controllato, al vivo, in condizioni in cui molteplici fattori possono influire negativamente sulle piante, ancora poco adattate alle condizioni».
Non solo orchidee
Ad essere coltivate in vitro, a dire la verità, non ci sono solo le orchidee, ma da questa estate si è aggiunto anche il Limonium etruscum, una specie endemica locale, sotto i 1.000 esemplari, rintracciabile solo nelle coste del Parco della Maremma.

“Perché non provare a tutelarla? – dice ovviamente Moncini – il progetto è partito nell’estate 2021, e tutto lascia sperare in un buon risultato, siamo comunque cauti e aspettiamo di terminare i cicli sperimentali prima di comunicarne i risultati”.
Il CRISBA quindi si attesta sempre più come un centro di eccellenza del nostro territorio, oltretutto nel cuore della città capoluogo, Grosseto. Ad attendere il suo prossimo passo, sembrerebbe ancora un nuovo traguardo tagliato con successo.
Contatti (Crisba): sito internet – Pagina Facebook – Instagram
LEGGI ANCHE:
Al Lorena prima studi poi entri subito al lavoro | MaremmaOggi
Diventare estetista è facile: basta iscriversi al Lorena | MaremmaOggi
Al Lorena si diventa tecnici chimici e biotecnologici | MaremmaOggi
Al Lorena come essere al grand hotel | MaremmaOggi
Le giornate aperte dell’istituto Leopoldo II di Lorena | MaremmaOggi
Leopoldo di Lorena, la scuola che promuove il territorio | MaremmaOggi